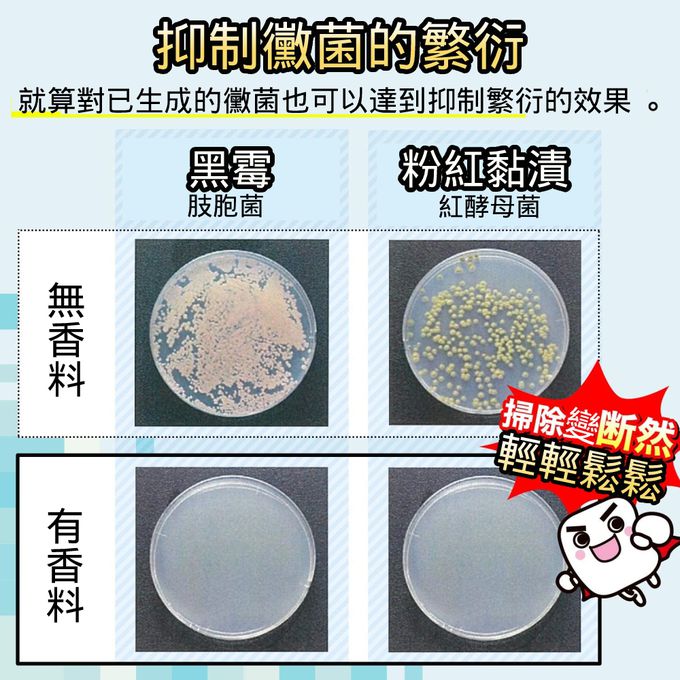

首載 App 現領 $ 100 折價券
 ( 10000+ )
( 10000+ )
1/2
日本 LEC - 激落君浴室防黴用芳香除臭劑-5入組
已售出 1
商品編號:825601
滿件折 滿2件85折
進團購
市售價
$ 1390
促銷價
$ 1190
86折
5% 回饋
數量
1
現貨
付款後 1~3 個工作天 出貨
商品特色
貼在天花板就可有效預防肉眼看不到黑黴菌種
透明薄膜可明確看到劑量存量即時替換
特殊薄膜可以防止水氣進入有效成分蒸散出去
抗菌抗黴香料可抑制黴菌的生成,打掃更輕鬆

口碑嚴選

正品保證

加密付款

7天鑑賞
付款
信用卡・LINE Pay・街口支付・先享後付・ATM
配送
宅配
滿$799免運
介紹

【產地】台灣
【數量】5入組
【容量】6.5mL x5入
【保存期限】5年
【使用及替換頻度】浴室尺寸1坪大小適用1個,視使用狀況約可使用2個月。
【用途】浴室內防黴。
【使用方法】
●為加強防黴效果,請在使用本品前建議先將明顯的黴菌除去後再使用。
※針對已經產生的黴菌有抑制擴散的效果,就算有黴菌的狀態下也是可以使用。
●為使防黴效果更佳,建議2個月做一次替換,就可以不需要常使用除黴商品打掃保持浴室清潔乾淨。
●1.由固定盒中取出除黴芳香包。
●2.撕下外側的鋁膜貼紙。 ※請千萬不要撕掉中間剩下的透明薄膠膜喔。
●3.將透明薄膠膜朝向正面放回固定盒中。
●4.先清潔預計要貼附的地方(天花板) ,將水分和油分擦乾淨後,用固定盒反面的雙面膠貼上即可。※因天花板材質不同可能無法貼合,請貼在壁面靠近天花板處即可。
【保存方法】勿近火源或置於高溫潮濕、陽光直射處。
【主要成分】抗菌抗黴香料、增黏劑、色素。
看更多


